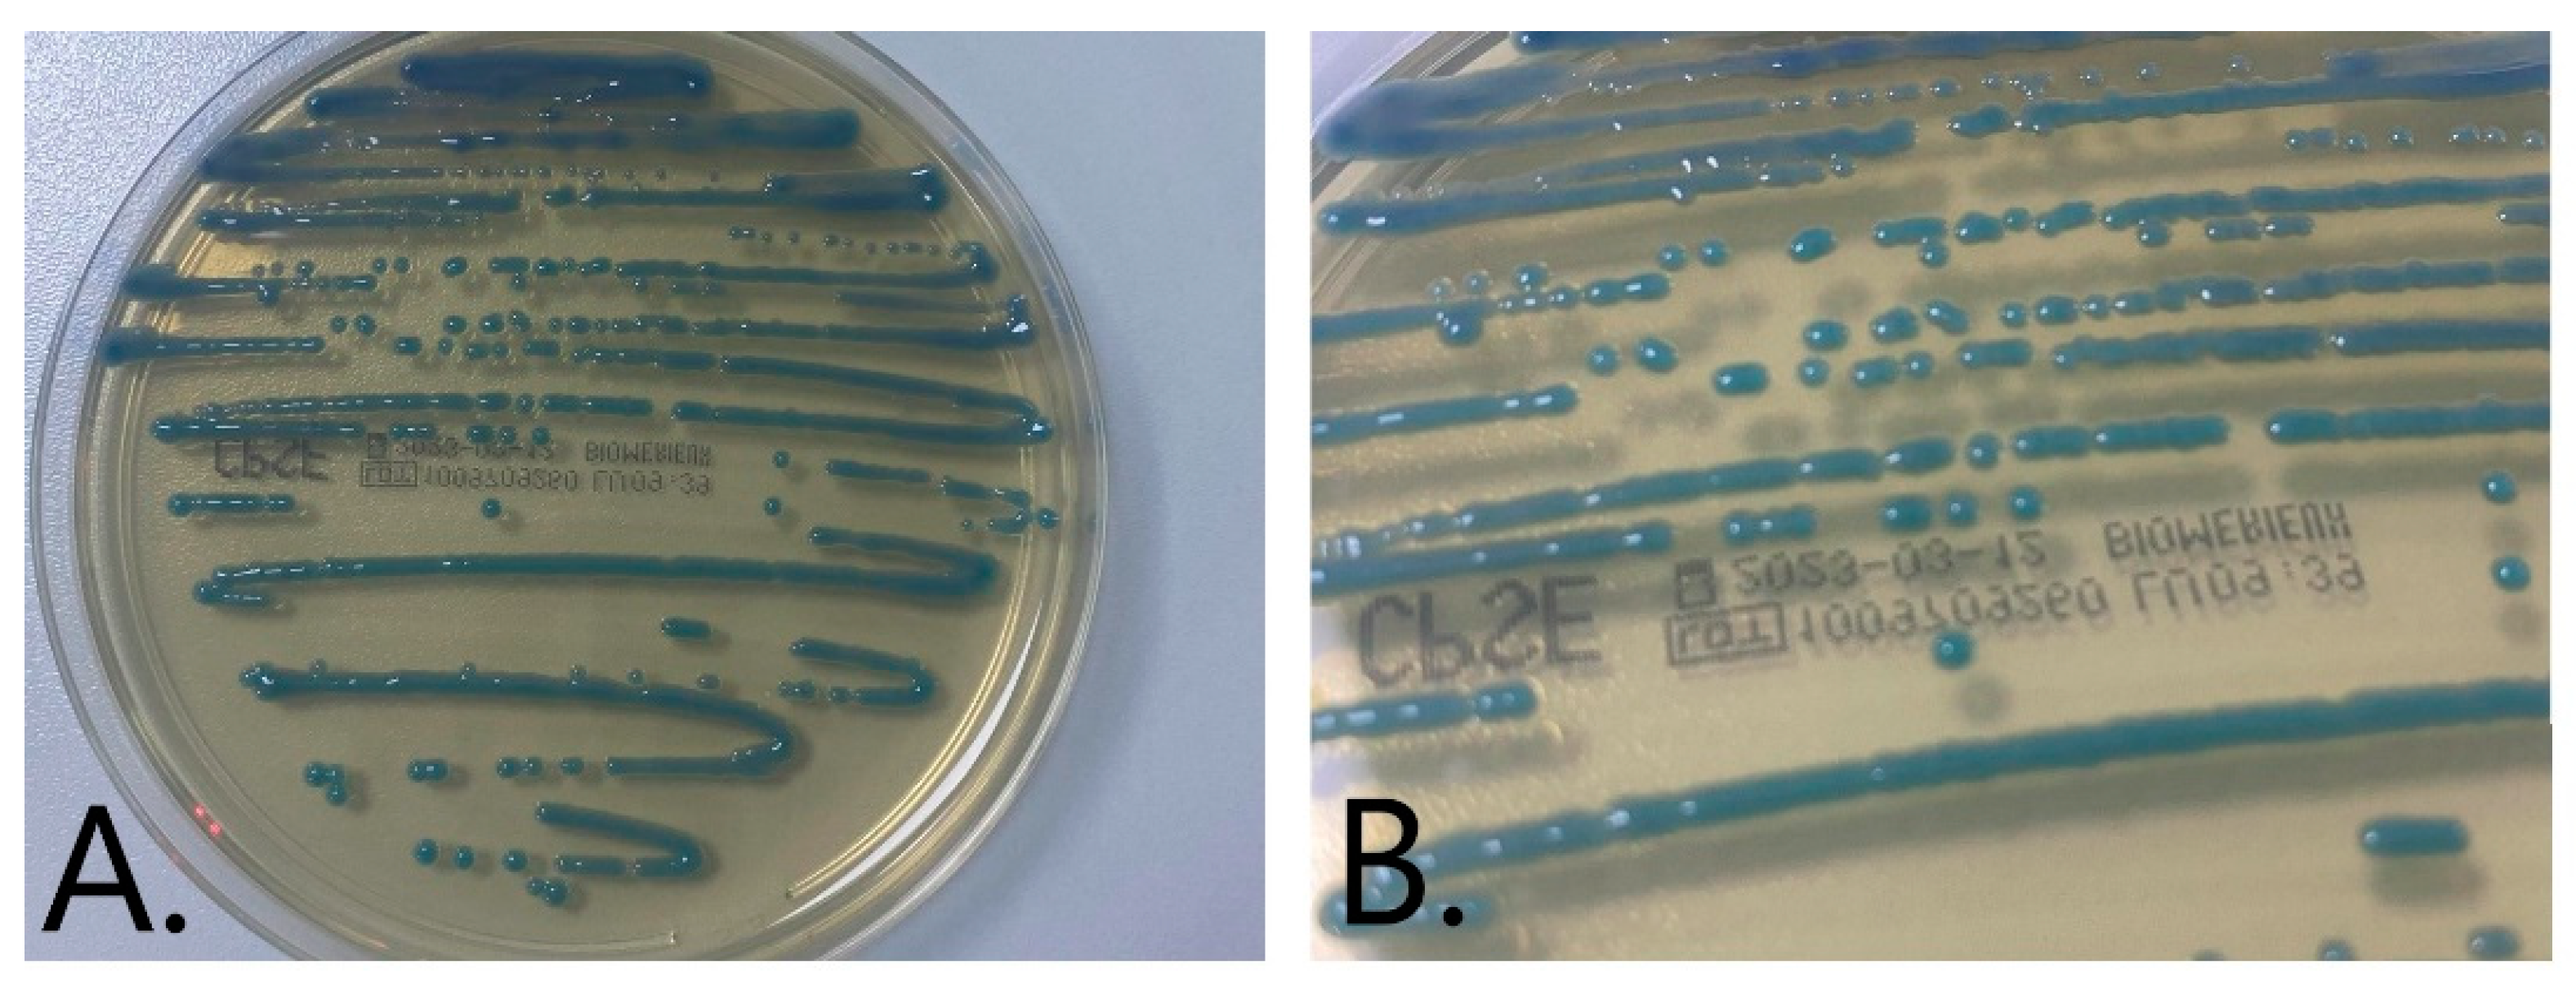
Medicina 59 00506 g002

First Case of Raoultella planticola Urinary Tract Infection Reported in Western Romania
Abstract
1. Introduction
2. Materials and Methods
2.1. Patient
2.2. Specimen Collection
2.3. Laboratory Assays
2.4. Microbiology Techniques and Assays
2.5. Ethical Approval
3. Results
4. Discussion
5. Conclusions
Author Contributions
Funding
Institutional Review Board Statement
Informed Consent Statement
Data Availability Statement
Conflicts of Interest
References
- Petca, R.-C.; Mareș, C.; Petca, A.; Negoiță, S.; Popescu, R.-I.; Boț, M.; Barabás, E.; Chibelean, C.B. Spectrum and Antibiotic Resistance of Uropathogens in Romanian Females. Antibiotics 2020, 9, 472. [Google Scholar] [CrossRef] [PubMed]
- Stamm, W.E.; Norrby, S.R. Urinary tract infections: Disease panorama and challenges. J. Infect. Dis. 2001, 183 (Suppl. S1). [Google Scholar] [CrossRef] [PubMed]
- Chita, T.; Timar, B.; Muntean, D.; Bădițoiu, L.; Horhat, F.G.; Hogea, E.; Moldovan, R.; Timar, R.; Licker, M. Urinary tract infections in Romanian patients with diabetes: Prevalence, etiology, and risk factors. Ther. Clin. Risk Manag. 2017, 13, 1–7. [Google Scholar] [CrossRef]
- Kahlmeter, G. An international survey of the antimicrobial susceptibility of pathogens from uncomplicated urinary tract infections: The ECO.SENS Project. J. Antimicrob. Chemother. 2003, 51, 69–76. [Google Scholar] [CrossRef]
- Fager, C.; Yurteri-Kaplan, L. Urinary tract infection with rare pathogen Raoultella planticola: A post-operative case and review. Urol. Case. Rep. 2019, 22, 76–79. [Google Scholar] [CrossRef] [PubMed]
- Chun, S.; Yun, J.W.; Huh, H.J.; Lee, N.Y. Low virulence? Clinical characteristics of Raoultella planticola bacteremia. Infection 2014, 42, 899–904. [Google Scholar] [CrossRef]
- Demiray, T.; Koroglu, M.; Ozbek, A.; Altindis, M. A rare cause of infection, Raoultella planticola: Emerging threat and new reservoir for carbapenem resistance. Infection 2016, 44, 713–717. [Google Scholar] [CrossRef]
- Gonzales Zamora, J.; Corzo-Pedroza, M.; Romero Alvarez, M.; Martinez, O. Carbapenemase-Producing Raoultella planticola: A Rare Cause of Pneumonia and Bacteremia. Diseases 2018, 6, 94. [Google Scholar] [CrossRef] [PubMed]
- Lam, P.W.; Salit, I.E. Raoultella planticola bacteremia following consumption of seafood. Can. J. Infect. Dis. Med. Microbiol. 2014, 25, e83–e84. [Google Scholar] [CrossRef]
- Yarbrough, M.L.; Wallace, M.A.; Marshall, C.; Mathias, E.; Burnham, C.A. Culture of Urine Specimens by Use of chromID CPS Elite Medium Can Expedite Escherichia coli Identification and Reduce Hands-On Time in the Clinical Laboratory. J. Clin. Microbiol. 2016, 54, 2767–2773. [Google Scholar] [CrossRef]
- Książczyk, M.; Dudek, B.; Kuczkowski, M.; O’Hara, R.; Korzekwa, K.; Wzorek, A.; Korzeniowska-Kowal, A.; Upton, M.; Junka, A.; Wieliczko, A.; et al. Application of Routine Diagnostic Procedure, VITEK 2 Compact, MALDI-TOF MS, and PCR Assays in Identification Procedure of Bacterial Strain with Ambiguous Phenotype. Curr. Microbiol. 2016, 72, 570–582. [Google Scholar] [CrossRef]
- Olson, D.S.; Asare, K.; Lyons, M.; Hofinger, D.M. A novel case of Raoultella planticola urinary tract infection. Infection 2013, 41, 259–261. [Google Scholar] [CrossRef]
- Mehmood, H.; Pervin, N.; Israr Ul Haq, M.; Kamal, K.R.; Marwat, A.; Khan, M. A Rare Case of Raoultella planticola Urinary Tract Infection in a Patient With Immunoglobulin A Nephropathy. J. Investig. Med. High Impact Case Rep. 2018, 6, 2324709618780422. [Google Scholar] [CrossRef] [PubMed]
- Bagley, S.T. Habitat association of Klebsiella species. Infect. Control IC 1985, 6, 52–58. [Google Scholar] [CrossRef]
- Bagley, S.T.; Seidler, R.J.; Brenner, D.J. Klebsiella planticola sp. nov.: A new species of enterobacteriaceae found primarily in nonclinical environments. Curr. Microbiol. 1981, 6, 105–109. [Google Scholar] [CrossRef]
- Tuğcu, M.; Ruhi, C.; Gokce, A.M.; Kara, M.; Aksaray, S. A case of urinary tract infection caused by Raoultella planticola after a urodynamic study. Braz. J. Infect. Dis. Off. Publ. Braz. Soc. Infect. Dis. 2017, 21, 196–198. [Google Scholar] [CrossRef]
- Skelton, W.P.; Taylor, Z.; Hsu, J. A rare case of Raoultella planticola urinary tract infection in an immunocompromised patient with multiple myeloma. IDCases 2017, 8, 9–11. [Google Scholar] [CrossRef] [PubMed]
- Alampoondi Venkataramanan, S.V.; George, L.; Sahu, K.K.; Abraham, G.M. A 5-Year Retrospective Analysis of Raoultella planticola Bacteriuria. Infect. Drug Resist. 2021, 14, 1989–2001. [Google Scholar] [CrossRef] [PubMed]
- Henry, T.; García-Del Portillo, F.; Gorvel, J.P. Identification of Salmonella functions critical for bacterial cell division within eukaryotic cells. Mol. Microbiol. 2005, 56, 252–267. [Google Scholar] [CrossRef] [PubMed]
- Wagenlehner, F.M.; Lichtenstern, C.; Rolfes, C.; Mayer, K.; Uhle, F.; Weidner, W.; Weigand, M.A. Diagnosis and management for urosepsis. Int. J. Urol. Off. J. Jpn. Urol. Assoc. 2013, 20, 963–970. [Google Scholar] [CrossRef]
- Rosenthal, E.J.K. Epidemiology of septicaemia pathogens. Dtsch. Med. Wochenschr. 1946 2002, 127, 2435–2440. [Google Scholar] [CrossRef] [PubMed]
- Funke, G.; Funke-Kissling, P. Evaluation of the new VITEK 2 card for identification of clinically relevant gram-negative rods. J. Clin. Microbiol. 2004, 42, 4067–4071. [Google Scholar] [CrossRef]
- Sekowska, A.; Mikucka, A.; Gospodarek-Komkowska, E. Identification of Raoultella spp.: Comparison of three methods. Indian J. Med. Microbiol. 2018, 36, 197–200. [Google Scholar] [CrossRef] [PubMed]
- Puig, C.R.D.A.; Torres, M.F.; Marfil-Pérez, E.; Ferández, M.I.R.; Del Río, M.C.; Balbín, J.A.; Martínez-Martínez, L. Comparison between Vitek MS, Bruker Biotyper, Vitek2, and API20E for differentiation of species of the genus Raoultella. Eur. J. Clin. Microbiol. Infect. Dis. Off. Publ. Eur. Soc. Clin. Microbiol. 2019, 38, 467–470. [Google Scholar] [CrossRef] [PubMed]
- Rowe, T.A.; Juthani-Mehta, M. Diagnosis and management of urinary tract infection in older adults. Infect. Dis. Clin. N. Am. 2014, 28, 75–89. [Google Scholar] [CrossRef] [PubMed]
- Stock, I.; Wiedemann, B. Natural antibiotic susceptibility of Klebsiella pneumoniae, K. oxytoca, K. planticola, K. ornithinolytica and K. terrigena strains. J. Med. Microbiol. 2001, 50, 396–406. [Google Scholar] [CrossRef]
- Castanheira, M.; Deshpande, L.M.; DiPersio, J.R.; Kang, J.; Weinstein, M.P.; Jones, R.N. First descriptions of blaKPC in Raoultella spp. (R. planticola and R. ornithinolytica): Report from the SENTRY Antimicrobial Surveillance Program. J. Clin. Microbiol. 2009, 47, 4129–4130. [Google Scholar] [CrossRef]
- Dason, S.; Dason, J.T.; Kapoor, A. Guidelines for the diagnosis and management of recurrent urinary tract infection in women. Can. Urol. Assoc. J. J. Assoc. Urol. Can. 2011, 5, 316–322. [Google Scholar] [CrossRef]
- EAU Guidelines Office. Edn. Presented at the EAU Annual Congress Amsterdam 2022; EAU Guidelines Office: Arnhem, The Netherlands, 2022; ISBN 978-94-92671-16-5. Available online: https://uroweb.org/guidelines/compilations-of-all-guidelines/ (accessed on 25 February 2023).

| Antibacterial | MIC * (mg/L) | Interpretation |
|---|---|---|
| Ampicillin | 16 | R |
| Amoxicillin/Clavulanic Acid | ≤2 | S |
| Piperacillin/Tazobactam | ≤4 | S |
| Cefotaxime | ≤1 | S |
| Ceftazidime | ≤1 | S |
| Cefepim | ≤1 | S |
| Ertapemen | ≤0.5 | S |
| Imipenem | 1 | S |
| Meropenem | ≤0.25 | S |
| Amikacin | ≤2 | S |
| Gentamicin | ≤1 | S |
| Ciproprofloxacin | ≤0.25 | S |
| Nitrofurantoin | ≤16 | S |
| Trimetoprime + sulfamethoxazole | ≤20 | S |
Disclaimer/Publisher’s Note: The statements, opinions and data contained in all publications are solely those of the individual author(s) and contributor(s) and not of MDPI and/or the editor(s). MDPI and/or the editor(s) disclaim responsibility for any injury to people or property resulting from any ideas, methods, instructions or products referred to in the content. |
© 2023 by the authors. Licensee MDPI, Basel, Switzerland. This article is an open access article distributed under the terms and conditions of the Creative Commons Attribution (CC BY) license (https://creativecommons.org/licenses/by/4.0/).
Share and Cite
Mihu, A.G.; Susan, M.M.; Strauti, C.N.; Mot, M.D.; Muresanu, H.D.; Balta, C.; Nesiu, A. First Case of Raoultella planticola Urinary Tract Infection Reported in Western Romania. Medicina 2023, 59, 506. https://doi.org/10.3390/medicina59030506
Mihu AG, Susan MM, Strauti CN, Mot MD, Muresanu HD, Balta C, Nesiu A. First Case of Raoultella planticola Urinary Tract Infection Reported in Western Romania. Medicina. 2023; 59(3):506. https://doi.org/10.3390/medicina59030506
Chicago/Turabian StyleMihu, Alin Gabriel, Monica Maria Susan, Carmen Nicoleta Strauti, Maria Daniela Mot, Horia Dan Muresanu, Cornel Balta, and Alexandru Nesiu. 2023. "First Case of Raoultella planticola Urinary Tract Infection Reported in Western Romania" Medicina 59, no. 3: 506. https://doi.org/10.3390/medicina59030506
APA StyleMihu, A. G., Susan, M. M., Strauti, C. N., Mot, M. D., Muresanu, H. D., Balta, C., & Nesiu, A. (2023). First Case of Raoultella planticola Urinary Tract Infection Reported in Western Romania. Medicina, 59(3), 506. https://doi.org/10.3390/medicina59030506

